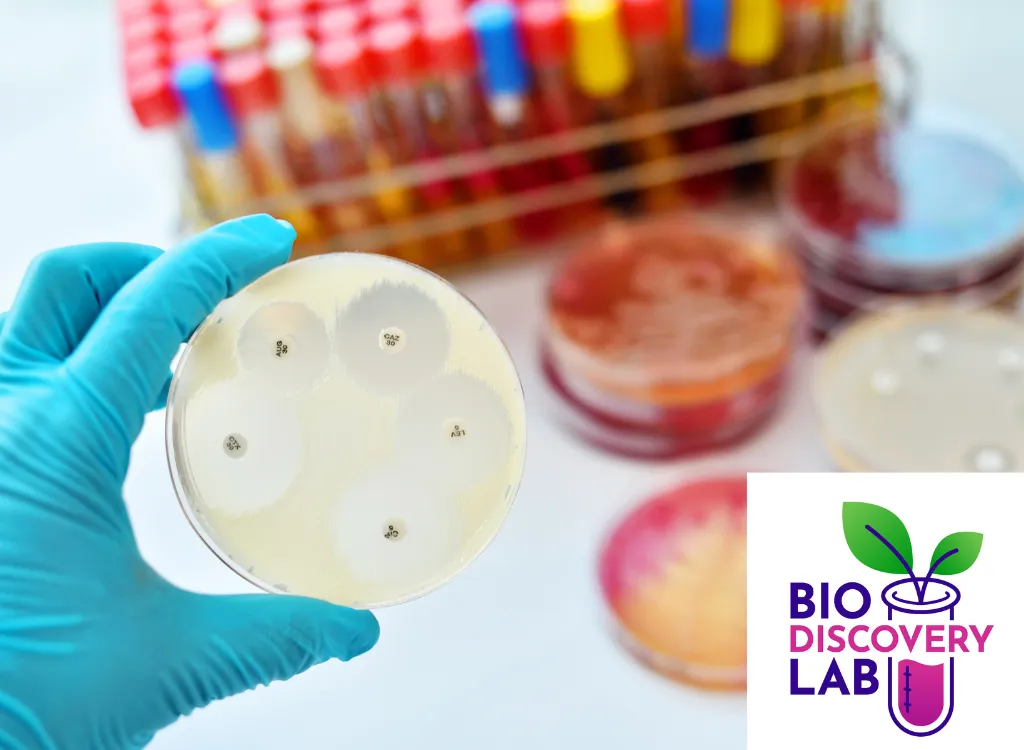

Experiments in Biotechnology
Join Kiewit Luminarium and Metropolitan Community College (MCC) for our workshop series: BioDiscovery Lab! Inspired by MCC’s new Biotechnology program, these interactive workshops explore the exciting world of biotechnology. Biotechnology uses living organisms to create products that benefit health, agriculture, and the environment. Blending biology, design, and technology, these activities spark curiosity and creativity, supporting both MCC’s and Kiewit Luminarium’s mission to inspire lifelong interest and careers in STEM.
These engaging workshops explore a variety of topics including bioplastics, microbes, bioluminescence, and more! Designed for youth ages 8 and up, plus their families, these workshops introduce cutting-edge tools, organisms, and immersive activities. Participants will explore biology as a powerful and accessible tool for problem-solving, encouraging everyone to imagine and engage with the future of biotechnology.
Questions? Reach out to us: [email protected]
Upcoming Labs
All workshops take place at Kiewit Luminarium in the second floor River Room. Sign up for an upcoming workshop today! Spots are limited. Workshops are included free with a general admission ticket or Membership.
BioDiscovery Lab: Bio-Ink
Get ready to be a scientist AND an artist! In this workshop, you’ll meet a special soil bacteria called…

BioDiscovery Lab: Making with Microbes
Ever wanted to create your own eco-friendly paper, plastic, or even animal-free leather? Now you can! In this immersive…

BioDiscovery Lab: Making with Microbes
Ever wanted to create your own eco-friendly paper, plastic, or even animal-free leather? Now you can! In this immersive…

BioDiscovery Lab: Cabbage Ink
This interactive experience explores the fascinating world of natural pigments. Using anthocyanin, a special pigment found in red cabbage,…

BioDiscovery Lab: Cabbage Ink
This interactive experience explores the fascinating world of natural pigments. Using anthocyanin, a special pigment found in red cabbage,…

BioDiscovery Lab: Bioluminescence
In this interactive workshop, you will explore the fascinating science of bioluminescence—the natural ability of organisms to produce light!…

BioDiscovery Lab: Bioluminescence
In this interactive workshop, you will explore the fascinating science of bioluminescence—the natural ability of organisms to produce light!…